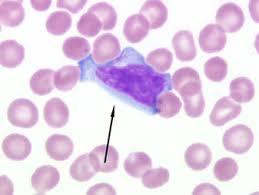

Genes associated with hereditary breast cancer and their function
BRCA1 and BRCA2
Tumor suppressor genes (involved in DNA repair) - both breast and ovarian
Mutation causes loss of function
Genes associated with acquired breast cancer and their function
HER2
Receptor tyrosine kinase
Mutation causes gain of function
What is acute intermittent porphyria (AIP) and what is the deficiency that causes it
Autosomal dominant disorder of heme synthesis pathway
Due to Porphobilinogen (PBG) deaminase deficiency
What are the toxic metabolites that build up in acute intermittent porphyria
Porphobilinogen, d-ALA
What is the treatment for acute intermittent porphyria
Heme and dextrose (these both inhibit ALA synthase)
Presentation of acute intermittent porphyria
Abd pain and vomiting, peripheral neuropathy, neuropsychological symptoms, reddish-brown urine
5 P’s:
Painful abd
Port-wine urine
Polyneuropathy
Psychological disturbance
Precipitated by drugs
What cellular process is the Kozak sequence involved in?
Initiation of translation in eukaryotes
GCCGCCGCC
What is the Shine-Dalgarno sequence?
Sequence required for initiation of translation in prokaryotes
AGGAGGU
What is the most common indolent non-Hodkin lymphoma and what is its presentation?
Follicular lymphoma
Waxing and waning course with painless lymph node enlargement
How do you differentiate CML (increased granulocytes and their precursors) from leukemoid reaction?
Leukemoid reaction will have a positive leukocyte alkaline phosphatase (LAP)
CML will have increased basophils
Definitive diagnosis requires t(9;22)
What is the enzyme that causes bruises to turn green while healing?
Heme oxygenase (which degrades the heme into biliverdin)
Biliverdin is then further reduced by biliverdin reductase to yellow pigment bilirubin to be transported to the liver bound to albumin
What is the function of Ristocetin test
Measures platelet aggregation by activating GP Ib receptor to make them available for vWF
in vWB disease there will be poor platelet aggregation in the presence of ristocetin
Aggregation will be corrected with addition of normal plasma (which contains vWF)
Aggregation will not be corrected with addition of normal plasma in Bernard-Soulier syndrome (GP Ib deficiency)
What disease is this atypical lymphocyte seen in?
EBV
Abundant pale cytoplasm with basophilic rim that is often indented by surrounding RBCs


